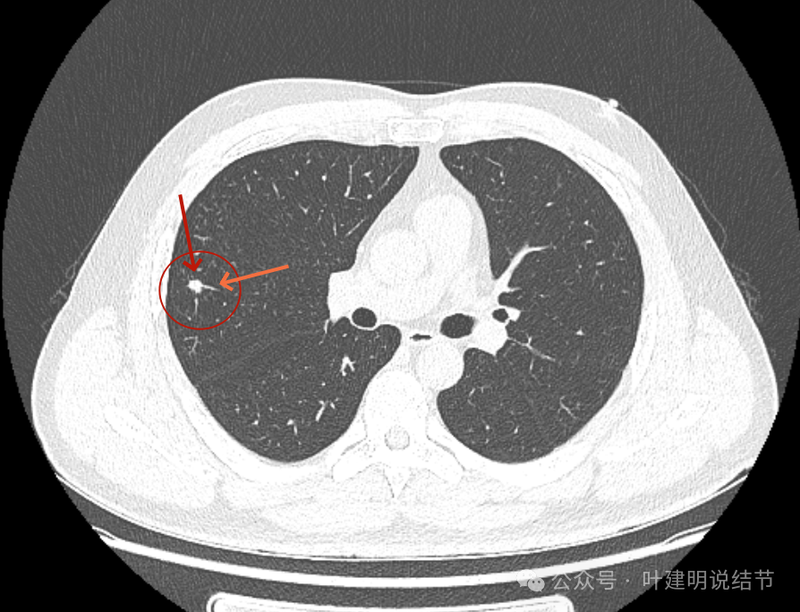
图片

前言:如果肺部查出小的实性结节,而血液肿瘤指标化验也有明显异常,这时候到底考不考虑是恶性程度高的肺癌?临床思维应该如何来评估决策,我想不同的医生真的会不一致的。作为患者自己也总更为纠结与担忧些。前段时间有位医生同道,他的亲戚查出肺结节,是实性的,而且也有神经元特异性烯醇化酶高于正常。这个指标有点吓人,中华医学会肺癌诊疗指南中有关的表述是这样的:NSE(神经元特异性烯醇化酶)和ProGRP(胃泌素释放肽前体)是诊断SCLC的首选指标。NSE由中枢或外周神经元以及神经外胚层性肿瘤分泌,当组织学结果无法确诊时,NSE可以辅助支持SCLC的诊断;溶血会显著影响NSE检测结果,应在60 min内与红细胞分离检测,防止假性升高。ProGRP作为单个标志物对SCLC诊断的特异度优于其他标志物,且与SCLC分期呈正相关,有助于鉴别SCLC和良性肺部疾病。ProGRP浓度升高也会出现在肾功能不全的患者中,其水平与血清肌酐有关,因此,当ProGRP水平升高而与患者临床症状不相符时,应首先评估患者的血清肌酐水平。我们来看看这位同道发给我的影像资料是个怎样的病灶,到底该如何来考虑。
病史信息:
叶医生你好,一个月之前,我在我们这边医院做的肺部CT片,李医生和您联系过,让我把电子版的22-24年CT发给您,我不能打开DCM格式的,里面可能也有脑CT,您有空时给看看肺部CT就可以,里面有结节,17年时只有一个4毫米结节,今年24年检查是6毫米,还有多发双肺结节,今天做的神经元特异性烯醇化酶(NSE)从一个月前的18.86增大到38.5,我很担心,麻烦您百忙之中有空时给看看肺部CT电子版,看看是怎么回事,是否有问题,下一步如何处理,谢谢叶医生!
影像展示与分析:
我们先来看2024年8月时的影像:

右上叶实性结节,边缘不光滑,有血管征,内部密度稍不均,整体轮廓较为清楚。

右中叶另处有斑点状多发实性结节,其中之一有小空泡征,也是轮廓与边界较为清楚的。

右中叶以及左上叶舌段也有多发偏模糊的实性结节影。

主病灶冠状位见血管紧挨,膨胀性不够。

主病灶矢状位见病灶略显模糊,边缘相对较为平直。
主病灶连续层面影像:

病灶出现,密度稍高。

密度高,表面不平不光滑,边上有小的点状高密度的卫星灶似的。
血管征明显。

边缘区显得毛糙。
与既往对比影像:

2022年10月主病灶处没有异常。

2022年时右中叶处本来就有的。
NSE结果:

我的意见:
右上这个结节实性,有血管征的样子,整体轮廓较清,如果从单次来看,是要考虑恶性可能性稍大些的,何况对比2022年时此灶不明显,那是新增的。但我觉得总体上看,倾向良性的一些:1、两肺,尤其是右中叶有多发斑点状实性小结了,较为散在,且对比2022年时无明显进展,说明肺部存在感染性的情况过,他处是遗留有慢性炎或肉芽肿性病变的基础在的,那么主病灶也是同样性质的可能性就增大了;2、冠状位与矢状位看,病灶的瘤肺边界不是很清楚,不像横断面上清楚,说明炎性的可能性是有的;3、实性病灶,但在纵向看,邻近血管并没有受到牵拉影响,没有形成血管弯征,说明收缩力或侵袭性不够。再加上病灶仍小,我的想法是考虑良性可能性大,并建议先4-6个月再复查下,期间也可试试口服莫西沙星消炎10-12天,若更进一步,也可查查结核与隐球菌方面的化验。意见供参考!
后续交流:
患:神经无特异性烯醇化酶高。
我:从影像上来看我是如前面考虑的,但若真是小细胞癌之类的,收缩力也可以不强。不过,恶性程度高的肿瘤的话,预后总归仍不好,即使现在切肺叶,也不是说就能治愈。位置在边上,如果不放心,单孔切了化验当然是最准确的。这要看自己如何权衡。个人总觉得目前还小,至少总再消炎,化验后观察至少3个月再说,如果3个月后转移了,现在开刀也没有用。
感悟:
这个病灶我是觉得要倾向良性些,但确实NSE增高达正常高限2倍以上,而小细胞肺癌确实也可以收缩力与膨胀性均不强的。要我说化验必为误差或正常的偏差实在也不敢保证。基于位置在边上,切了化验当然是可行的。但我总觉得当影像表现不是非常典型恶性,而病灶又还小的时候,何况加上他处多处有炎性实性小结节在的情况下,再随访下应该更为稳妥。退一步讲,就如我回复的意见中说的,如果真的是小细胞肺癌,现在切了难道就是能治愈吗?之所以可怕,是因为小细胞肺癌原发类很小就可以广泛的淋巴结转移与血行转移,而这并不是靠手术能完美解决的。我甚至碰到过之前观察几个月都稳定,切了后2个月内全向广泛转移的小细胞肺癌病例。在这种恶性程度高的肿瘤当中,外科干预促使肿瘤暴发性进展是有的。